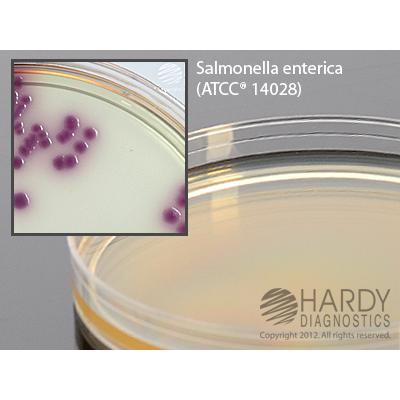
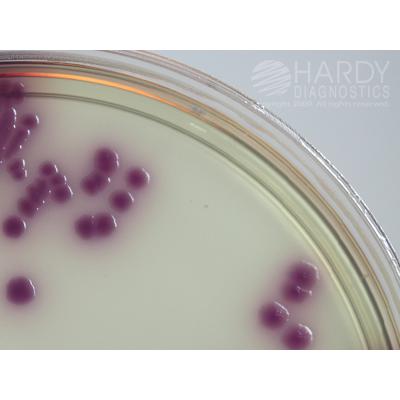

HardyCHROM™ Salmonella, an effective chromogenic screen of all Salmonella spp., 15x100mm plate, Hardy Diagnostics
| Image | SKU | Description | Quantity | Price | Add to Cart |
|---|---|---|---|---|---|

|
G309 | HardyCHROM Salmonella, 15x100mm plate | 10 Pack | $40 |
Description
HardyCHROM™ Salmonella is a differential medium that facilitates the isolation and differentiation of Salmonella spp. from other members of the family Enterobacteriaceae.
This media is to be stored and incubated in the dark.
This medium utilizes the ability of Salmonella spp. to produce acid from propylene glycol. This characteristic is used in conjunction with a chromogenic indicator to differentiate Salmonella spp. form Proteus spp. and other Enterobacteriaceae.
Salmonella spp., including S.typhi and S.paratyphi A, produce pink to magenta colonies as a result of propylene glycol utilization. Members of the family Enterobacteriaceae produce blue, blue-green, white, or colorless colonies, while gram-positive bacteria and non-glucose fermenting bacteria will be inhibited.
Summary
HardyCHROM™ Salmonella facilitates the isolation and differentiation of Salmonella spp. from other members of the family Enterobacteriaceae. Peptones in the medium supply the necessary nutrients. Selective agents inhibit the growth of gram-positive organisms. Artificial substrates (chromogens) are broken down by specific microbial enzymes which release insoluble colored compounds. Salmonella species break down only one of the chromogens and will produce deep pink to magenta colored colonies. Bacteria other than Salmonella spp. may break down the other chromogenic substrates and produce blue colonies. If none of the substrates are utilized, natural or white colored colonies will be present.
This product has a short shelf life and ships from California only.







